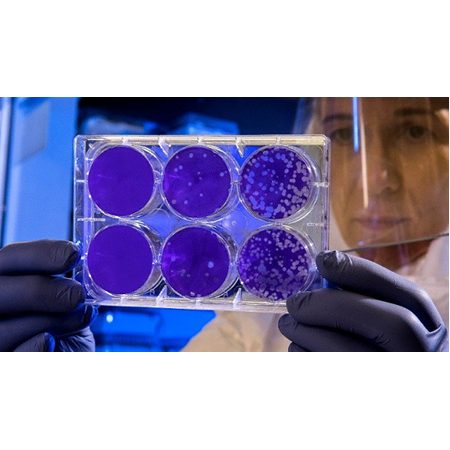

23 Eylül 2023
Akademik Araştırma Siteleri
Akademik Araştırma Siteleri Yeni araştırma ve ürün geliştirme çalışmalarından yarar sağlayacak ulusal ve uluslar arası araştırma siteleri. ? ULUSAL ARAŞTIRMA SİTELERİ ? YÖK Ulusal Tez Merkezi https://tez.yok.gov.tr/UlusalTezMerkezi/ Yükseköğretim Kurulu yüksek lisans ve doktora tezleri arşivi ? Dergi Park http://dergipark.gov.tr/ TÜBİTAK ULAKBİM çatısı altında faaliyet gösteren akademik dergi ve elektronik makale platformu ? MEGEP Modülleri http://www.megep.meb.gov.tr/?page=moduller MEB Mesleki ve Teknik Eğitim bireysel öğrenme materyalleri ? TR Dizin https://trdizin.gov.tr/ TÜBİTAK ULAKBİM veri tabanı ? ULAKBİM http://ulakbim.tubitak.gov.tr/ Ulusal Akademik Ağ ve Bilgi Merkezi ? TUBA